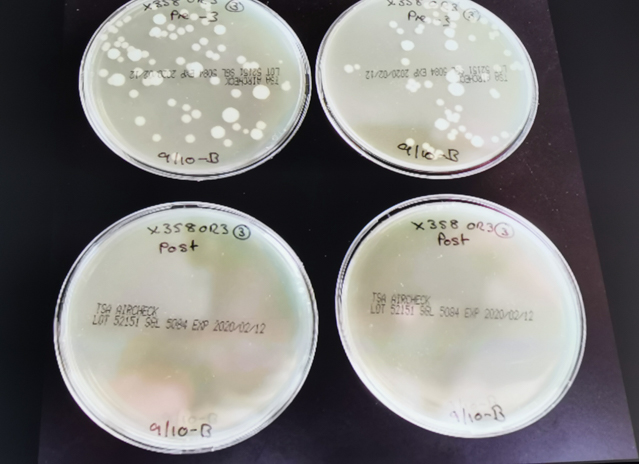

ダイソンから「加湿器」「空気清浄機」「扇風機」の機能を併せ持った加湿空気清浄機、『dyson pure humidify cool』が発表されました。しかし、この加湿器、今までの加湿器とかなり違うところがあります。それは、衛生を徹底したということです。

+cool なので温風機能はなし。
来年は dyson pure humidify + hot & cool かも知れない。

いつものダイソンらしい形。
ところで、スターウォーズの
オビ=ワン・ケノービとR2-D2に似ている
と思うのは私だけでしょうか?
■技術を煮詰め続けるダイソン 〜加湿器として〜
ダイソンは創業者がまだ、頑張っているためでしょうか?技術開発に執念深い会社です。どのメーカーは似た要素を持っていますが、日本とちょっと違います。それは、技術開発を、時間をかけ、徹底的に、強い言葉で言うと執念深く行う所です。
今回でいうと、「水の衛生」です。
生命に欠かせないのが、温度、水、栄養です。日本の場合、亜熱帯に近い温帯ですから、空気中に、微生物が一杯とんでいます。とは言うモノの、意志を持って飛んでいるわけではなく、胞子の状態で漂っているとかですが・・・。
暖かい日本では、これらが水に落ちますと、ただちに行動開始。彼らのエサは一緒に飛んでいるホコリの中にいっぱいあります。逆にないのが水です。このため、結露する(=水分がある)とカビが生えます。
ダイソンは効果を確認するため、
何度も培養試験を行ったという。
そんな国、日本も冬は乾燥。加湿器が欲しくなります。
加湿器は、水タンクがありますので、十分気を付けないと、微生物、特に黴菌を繁殖させる可能性があります。加湿器は、その水を使いますので、繁殖した黴菌を再度空気中に放つ恐れがあります。このため、加湿器に使う水は、水道水です。水道水は、ミネラルウォーターと違い、バクテリアもコントロールしてある水だからです。それでも繁殖するのが黴菌。本当にたくましいです。
また加湿器のタイプによっても変わります。
黴菌に対し、一番安全なのは、スチーム式です。水を沸騰させて、その水蒸気を使います。いわゆる煮沸消毒と同じです。
逆に、もっとも菌に有利なのは、超音波式です。超音波は、水⇒水蒸気と相変化を起こさずに、小さい水滴、水霧を水分を空気中に拡散する方式です。このため、水の中に菌がいる場合、そのまま空気中に放出する可能性があります。
空気中にもある割合で菌はいます。が、貯水タンクの中で繁殖した場合、その割合が増します。つまり空気中の菌の濃度が上がるわけです。当然健康被害がでます。
このため、各メーカーは、それを防ぐために、いろいろなことをします。最もポピュラーな衛生技術は銀イオンを使用するものです。銀イオンには殺菌作用があります。
欧米の食卓では、銀器がよく用いられます。それは安全性が高いからです。レミゼラブルの冒頭、ジャンバル・ジャンは教会から銀器を盗みます。何故、教会に銀器があるかというと、どんな時でも教会は人々の心の拠り所として開放されなければならないからです。ヨーロッパは、下水道が普及しなかったため、ペスト、赤痢などが流行しました。その時でも教会は門戸を開き続けなければならないわけですから。
多くの日本メーカーは、この銀イオンに、「清掃」で対応する様に求めます。ただ私は、これに対し疑問があります。加湿器の清掃は、正直面倒です。それが3日に1度などになると実に面倒です。「人は加湿器によって生きるにあらず。」と愚痴の一つもでます。特に、最近の加湿器は、24時間、365日出しっぱなしを前提にするモノが多いです。そうなると、なるべく清掃いらず、最低でも1週間に1度位にして欲しいと思います。
■銀イオン+紫外線消毒
ダイソンが提案したのは、銀イオンに、紫外線を組み合わせることでした。しかし、紫外線での滅菌はかなり時間が掛かります。理由の1つは光源から出た紫外線は四方八方に散るからです。つまり、光源の紫外線量=菌に浴びせる紫外線量、ではないため、菌もなかなか死なないのです。例えば、紫外線で内視鏡を滅菌する場合、4分以上かかります。
このため、ダイソンが考えたのは、給水時、水が細い通路を通るときに、叩く方法です。この細い水路の内部で、紫外線を反射させるようにすると、紫外線が逃げていきませんから、光源の紫外線量=菌に浴びせる紫外線量です。しかも、ユーザーが触れないようにできれば、光源自体のパワーを上げることも出来ます。狭エリアに紫外線を集中させることにより、瞬時に菌を殺すことができるようにしたのです。

マゼンダに光っているのが、
UV LEDで殺菌しているところ。
また銀は繊維状にして、フィルター内に編み込んであります。この繊維に編み込むのは有効な手で、水との表面積を増やすことができます。その上編み込まれているのがフィルター。必ず水が通るところです。このようにしてダイソンは、加湿器の難関、「衛生的であること」を突破したのです。

フィルター繊維拡大写真。
「つるん」とした銀繊維。
■エアコンができないことを、ほぼ網羅
空調には、次の要素のコントロールが必要とされています。
「CO2濃度(酸素濃度)」
「温度」
「湿度」
「風(気流)」
「浮遊粉じん物」
「VOC(揮発性有機化合物)」
この内「CO2濃度(酸素濃度)」は「換気」でしか対応できません。 家の密閉度が上がった今は、「24時間換気」が義務付けられていますが、ほとんどの場合、人は意識しません。
で、エアコンが頑張るのが、「温度」「湿度(除湿)」「風(一部)」です。
メーカーの努力で「加湿」「空気清浄機能」が付いたエアコンもありますが、まだまだ特殊ですので、置いておきます。
足らないのは「湿度(加湿)」「風(気流)」「浮遊粉じん物」「VOC(揮発性有機化合物)」となります。
dyson pure humidify coolは、これらに対応している空調機機です。
■そよ風に対応した「ブリーズモード」 〜扇風機として〜
ダイソンが羽なし扇風機を作ってから10年が経ちました。その間、いろいろな工夫がされてきました。ただ、日本の扇風機が得意なランダムな微風=そよ風を作るには至りませんでした。
今回ダイソンは、イギリス マルムズベリーにある研究所、敷地内8ヶ所で、4000万以上のデーターを3軸型超音波風速計により取りました。それから導き出されたのが、「ブリーズモード」と言われるプログラムです。

3軸型超音波風速計
このプログラムによりダイソンは、微風をモノにしたそうです。
会場の展示では、後ろ側のひらひらを動かすため、完全微風とは行きませんでしたが、ランダムであることは十分に伝わってきました。
■空気清浄機の恩恵
ダイソンの故郷イギリスの首都ロンドンは、今、EUで最も大気汚染がひどいエリアです。
シャーロック・ホームズ、切り裂きジャックと、爛熟の時代のロンドン名物は「霧」でした。何を隠そう正体は「スモッグ」。当時裕福だったロンドンは暖を取るため、これでもかという程石炭を焚くのですが、当然フィルターはありません。その上、ロンドンは空気の流れが悪い。このために起こったわけです。
その後、大英敵国の衰退と共に、キレイになったと聞いていたのですが、実際は全然別だったようですね。原因はクルマだそうです。
詳しいデーターもあります。2019年1月 欧州環境防衛基金が市内に約100台の計測器を設置し、とったデーターです。「ブリーズ・ロンドン」というプロジェクトの一環です。結果、調査エリアの40%以上が法定レベルを超える汚染(NO2)状態だったそうです。
また、大気質のモニターを子どものリュックに装着できるようにし、より細かなデーターもとったそうです。

大気分析装置が組み込まれたランドセル。
また、キングスカレッジの2015年の調査では、毎年9500人近くのロンドン市民が、大気汚染物質にさらされた結果、早死にしているとの結果報告がされています。
サディク・カーン ロンドン市長は、今年ロンドン中心部に「超低排出ゾーン(ULEZ:Ultra Low Emission Zone、ユーレズと発音)」を導入。排出量を20%削減、クルマ乗り入れを1日9400台減らしたところ、即座に変化が現れたといいます。
北京とどちらが酷いのかと言われると、北京より酷いという人がいるのが、今のロンドンの現状です。
名の通った、歴史ある先進国の首都が、この状態では様になりません。
日本でも悪いニュースがあります。
11月22日、福岡工業大環境科学研究所(福岡市東区)の研究チームが、福岡市内の大気に微細なマイクロプラスチックが浮遊していることを確認したことが、報道されたのです。
昨年から、大気中のマイクロプラスチックのことは、知っていました。海洋が有名ですが、欧米では、大気中も問題になるだろうとされてきました。そして、そうなったのですが、個人的にはちょっとビビっています。それは大気汚染されていないエリアがない可能があるからです。

外側の厚く白いのが、空清のフィルター。
ダイソンはセルロースを使った独自構造。
中央オレンジの中に入っているのが、
銀繊維を織り込んだ水フィルター。
こんな時頼れるのは空気清浄機です。
さて、実はかなり選びにくいのが空気清浄機。理由は、テスト規格が幾つもあることに由来します。
現在、日本で一番多く使われているのが、JEMA(日本電機工業会)規格。これは8畳程度の空間を30分でどの位キレイにするのかを見ます。30分というのは、換気が部屋ごと、2回/時間とされているからです。
もうひとつ使われているのがAHAM(米国家電製品協会)規格が定めたCADR(Clean Air Delivery Rate:1分間あたりに供給する清浄な空気の量)値。煎じ詰めて言いますと、日本独自規格より厳しいものです。
大気汚染で有名な中国では、AHAMを基にGB規格(中国の独自規格)を作っており、今現在、最も厳しい規格と言われています。
しかし、ダイソンは、独自方式「ポーラー」でのテストを実施しています。これは新しい規格を作ったと言うより、テスト条件をより厳しくしたものです。部屋のサイズを大きくし、テスト機以外空気撹拌はなし。そして空気清浄機の位置は端置きです。どんな環境下でも、正確に、確実に、空気清浄をこなしてくれる。今の大きな課題です。

白い部分全体が、ポーラーで使用される。(6×4.5×3m)
赤い部分が一般的なテストで用いられる。(3.7×3.2×2.4m)
■室内空気のデーターが取れるのも魅力
今、家電はIoT化を進めていますが、dyson pure humidify coolも例外ではありません。
私は、空気清浄機のIoT化には、とても賛成です。理由は2つあります。
1つは、最も効率の良い運転をするためです。
2つめは「温度」「湿度」「浮遊粉じん物(PM2.5、PM10)」「VOC(揮発性有機化合物)」「NO2」など、自分の置かれている環境履歴がわかることです。
大気は、目で認識することができません。「可視化」は不可欠です。
自分のいる状況が分からなければ、対処のしようがありません。
今回の「dyson pure humidify cool」はかなりの力作と言えます。
ッ
商品のより詳しい情報は、ダイソンのホームページにてご確認ください。
http://www.dyson.co.jp
#空調家電 #ダイソン #dyson #dyson pure humidify cool #加湿器 #扇風機 #空気清浄機 #ダイソン ピュア ヒュミディファィ クール #生活家電.com

 RSS
RSS












